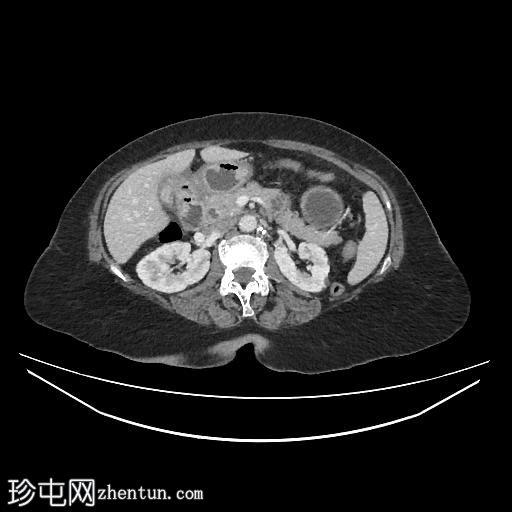
2.jpg

病例介绍
患者有反复右上腹疼痛病史,此次就诊时表现为胆汁性呕吐和腹胀。
患者资料
年龄:65岁
性别:女
CT
轴位
平扫

轴位增强扫描(门静脉期)
轴位增强扫描(门静脉期)

冠状位增强扫描(门静脉期)

矢状位增强扫描(门静脉期)

胆囊缩小,囊壁增厚,提示慢性炎症改变。胆囊(底部)与十二指肠(球部)腔之间可见细小瘘管,胆囊内及肝内、肝外胆管内均可见气体(胆道积气)。
远端空肠内嵌顿一枚较大的胆结石(3.5 cm),近端空肠袢扩张,回肠袢、末端回肠及结肠均塌陷。
病例讨论
胆石性肠梗阻是慢性胆囊炎伴胆囊十二指肠瘘的一种罕见并发症,胆结石可进入消化道,造成机械性小肠梗阻。
本病例符合典型的里格勒三联征:
异位胆结石
小肠梗阻
胆道积气 |